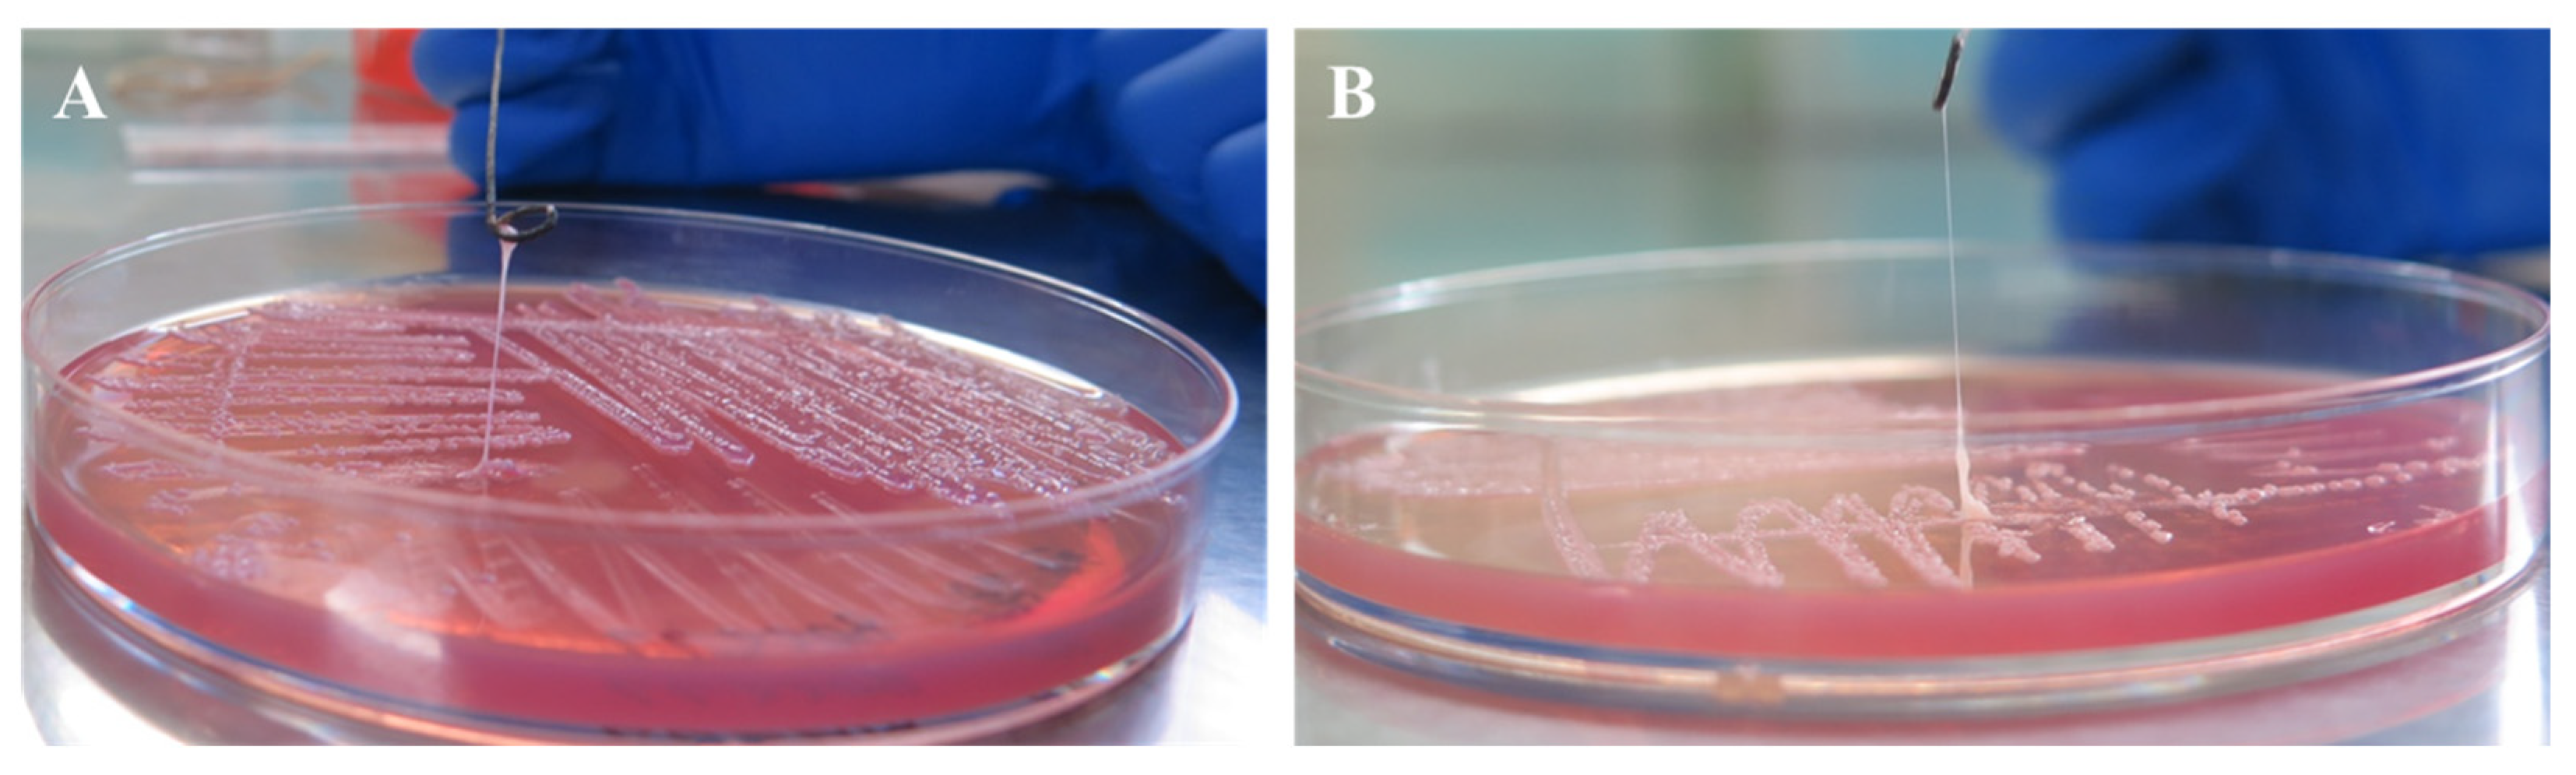
Pathogens 13 00647 g004 Pathogens 13 00647 g004

Hypermucoviscous Multidrug-Resistant Klebsiella variicola Strain LL2208 Isolated from Chinese Longsnout Catfish (Leiocassis longirostris): Highly Similar to Human K. variicola Strains
Abstract
1. Introduction
2. Materials and Methods
2.1. Bacterial Isolation and Identification
2.2. String Test
2.3. Biofilm Formation Assay
2.4. Challenge Test
- “Xk” is the logarithmic value of the maximum dose;
- “i” is the logarithmic dose difference between adjacent dose groups;
- “∑p” is the sum of mortality rates for each dose group.
2.5. Antimicrobial Susceptibility Testing
2.6. Whole-Genome Sequencing and Bioinformatics Analysis
2.6.1. Sequencing and Functional Genes Prediction
2.6.2. ANI and dDDH Analysis
2.6.3. Virulence-Related Genes
2.6.4. Antimicrobial Resistance Genes
2.6.5. Collinearity Analysis
3. Results
3.1. Bacterial Isolation and Identification
3.2. String Test
3.3. Biofilm Formation Ability
3.4. Pathogenicity
3.5. Antimicrobial Susceptibility
3.6. Genomic Sequencing and Bioinformatics Analysis
3.6.1. Genomic Annotation and Features
3.6.2. ANI and dDDH Analysis
3.6.3. Virulence-Associated Genes
3.6.4. Antimicrobial Resistance Genes
3.6.5. Collinearity Relationship
4. Discussion
5. Conclusions
Supplementary Materials
Author Contributions
Funding
Institutional Review Board Statement
Informed Consent Statement
Data Availability Statement
Acknowledgments
Conflicts of Interest
References
- Yin, L.; Shen, X.H.; Ma, H.T.; Pan, X.C.; Zhang, D.J.; Zhao, R.H.; Dai, Y.; Hou, H.Y.; Hu, X.M. Comprehensive genomic analysis and characterization of a new ST 174 type Klebsiella variicola strain isolated from chicken embryos. Infect. Genet. Evol. 2021, 90, 104768. [Google Scholar]
- Guo, Y.T.; Zhai, Y.; Zhang, Z.; Li, D.X.; Wang, Z.W.; Li, J.Q.; He, Z.L.; Hu, S.N.; Kang, Y.; Gao, Z.C. Complete genomic analysis of a kingdom-crossing Klebsiella variicola isolate. Front. Microbiol. 2018, 9, 2428. [Google Scholar] [CrossRef] [PubMed]
- China Antimicrobial Resistance Surveillance System. Antimicrobial resistance surveillance reports from respiratory medicine departments from China Antimicrobial Resistance Surveillance System in 2021. China J. Nosocomiol. 2023, 33, 3380–3386. (In Chinese) [Google Scholar]
- Pan, Y.X.; Wang, W.J.; Chen, Q.D.; Hu, G.W. Isolation, identification, and pathogenic analysis of Klebsiella pneumoniae from large yellow croaker Larimichthys crocea. Fish. Sci. 2023, 42, 268–278. (In Chinese) [Google Scholar]
- Teng, T.; Liang, L.G.; Xie, J.; Xu, P. Isolation and identification of pathogenic Klebsiella pneumoniae from Megalobrama amhlycephala. J. Hydroecol. 2016, 37, 95–100. (In Chinese) [Google Scholar]
- Cao, X.Y.; Huang, J.Y.; Du, S.Y.; Hou, T.M.; Xiang, W.; Gao, W.H.; Zhang, F.X. Isolation and characterization of Klebsiella pneumoniae type ST 873 from Micropterus salmoides. Oceanol. Limnol. Sin. 2023, 54, 836–847. (In Chinese) [Google Scholar]
- Dong, J.; Zhang, L.S.; Liu, S.C.; Zhang, G.D.; Zhou, S.; Yang, Q.H.; Ai, X.H. Isolation, identification and susceptibility analysis of pathogenic Klebsiella pneumonia from diseased Procambarus clarkii. J. Huazhong Agric. Univ. 2021, 40, 93–98. (In Chinese) [Google Scholar]
- Tan, A.P.; Deng, Y.T.; Jiang, L.; Wu, Y.L.; Xue, H.J.; Wang, W.L.; Luo, L.; Zhao, F. Isolation and identification of a multiple-drugresistant Klebsiella pneumoniae from Anguilla marmorata. Acta Hydrobiol. Sin. 2013, 37, 744–750. (In Chinese) [Google Scholar]
- Li, X.Y.; Zhou, W.P.; Fan, W.J. The partial biological characteristics and pathogenic analysis of Klebsiella pneumoniae from Chinese Giant salamander. Chin. J. Prev. Vet. Med. 2017, 39, 628–632. (In Chinese) [Google Scholar]
- Vaneci-Silva, D.; Assane, I.M.; de Oliveira Alves, L.; Gomes, F.C.; Moro, E.B.; Kotzent, S.; Pitondo-Silva, A.; Pilarski, F. Klebsiella pneumoniae causing mass mortality in juvenile Nile tilapia in Brazil: Isolation, characterization, pathogenicity and phylogenetic relationship with other environmental and pathogenic strains from livestock and human sources. Aquaculture 2022, 546, 737376. [Google Scholar] [CrossRef]
- Lin, H.; Ma, J.; Sun, J.Y.; Qin, Z.D.; Jiang, B.; Li, W.; Wang, Q.; Su, Y.L.; Lin, L.; Liu, C. Identification and characterization of Klebsiella pneumoniae from farmed American bullfrogs (Rana catesbeiana). Microbiol. Spectr. 2023, 11, e3522–e3579. [Google Scholar] [CrossRef] [PubMed]
- Rodríguez-Medina, N.; Barrios-Camacho, H.; Duran-Bedolla, J.; Garza-Ramos, U. Klebsiella variicola: An emerging pathogen in humans. Emerg. Microbes Infect 2019, 8, 973–988. [Google Scholar] [CrossRef] [PubMed]
- Maatallah, M.; Vading, M.; Kabir, M.H.; Bakhrouf, A.; Kalin, M.; Nauclér, P.; Brisse, S.; Giske, C.G. Klebsiella variicola is a frequent cause of bloodstream infection in the stockholm area, and associated with higher mortality compared to K. pneumoniae. PLoS ONE 2014, 9, e113539. [Google Scholar] [CrossRef]
- Long, D.L.; Wang, Y.H.; Wang, J.L.; Mu, S.J.; Chen, L.; Shi, X.Q.; Li, J.Q. Fatal community-acquired bloodstream infection caused by Klebsiella variicola: A case report. World J. Clin. Cases 2022, 10, 2474–2483. [Google Scholar] [CrossRef]
- Nakamura-Silva, R.; Macedo, L.M.D.; Cerdeira, L.; Oliveira-Silva, M.; Silva-Sousa, Y.T.C.; Pitondo-Silva, A. First report of hypermucoviscous Klebsiella variicola subsp. variicola causing primary endodontic infection. Clin. Microbiol. Infect. 2021, 27, 303–304. [Google Scholar] [CrossRef]
- Wang, B.; Pan, F.; Han, D.; Zhao, W.; Shi, Y.; Sun, Y.; Wang, C.; Zhang, T.; Zhang, H. Genetic characteristics and microbiological profile of hypermucoviscous multidrug-resistant Klebsiella variicola coproducing IMP-4 and NDM-1 carbapenemases. Microbiol. Spectr. 2022, 10, e01581-21. [Google Scholar] [CrossRef]
- Mondo, E.; Rinnovati, R.; Spadari, A.; Giacometti, F.; Serraino, A.; Savini, F.; Piva, S. First isolation of Klebsiella variicola from a horse pleural effusion. BMC Vet. Res. 2021, 17, 75. [Google Scholar] [CrossRef] [PubMed]
- Narendrakumar, L.; Sudhagar, A.; Preena, P.G.; Nithianantham, S.R.; Mohandas, S.P.; Swaminathan, T.R. Detection of Mycobacterium marinum and multidrug-resistant bacteria in a chronic progressive disease outbreak among Siamese fighting fish (Betta splendens) in India. Biologia 2022, 77, 2725–2733. [Google Scholar] [CrossRef]
- Dong, N.; Yang, X.; Chan, E.W.-C.; Zhang, R.; Chen, S. Klebsiella species: Taxonomy, hypervirulence and multidrug resistance. eBioMedicine 2022, 79, 103998. [Google Scholar] [CrossRef]
- Ge, H.; Qiao, J.; Xu, H.; Liu, R.; Zhao, J.; Chen, R.; Li, C.; Chen, M.; Guo, X. Emergence of OXA-484-producing Klebsiella variicola in China. Infect. Drug Resist. 2023, 16, 1767–1775. [Google Scholar] [CrossRef]
- Lenzi, M.H.; Martins, W.M.B.S.; Roch, M.; Ramos, P.L.; Sands, K.; Cayô, R.; Walsh, T.R.; Andrey, D.O.; Gales, A.C. A new mutation in mgrb mediating polymyxin resistance in Klebsiella variicola. Int. J. Antimicrob. Agents 2021, 58, 106424. [Google Scholar] [CrossRef] [PubMed]
- Garza-Ramos, U.; Rodriguez-Medina, N.; Lozano-Aguirre, L.; Silva-Sanchez, J.; Sanchez-Arias, M.; Rodriguez-Olguin, J.; Martínez-Romero, E. Klebsiella variicola reference strain F2R9 (ATCC BAA-830) genome sequence. Microbiol. Resour. Ann. 2021, 10, e00329-21. [Google Scholar] [CrossRef] [PubMed]
- Srinivasan, V.B.; Rajamohan, G. Comparative genome analysis and characterization of a MDR Klebsiella variicola. Genomics 2020, 5, 3179–3190. [Google Scholar] [CrossRef] [PubMed]
- Zhao, W.; Zhou, J.; Li, Z.; Jing, T.; Zhao, L.; Ye, H. Characterization of 55 SNP markers in Chinese longsnout catfish Leriocassis Longirostris. Conserv. Genet. Resour. 2020, 12, 427–432. [Google Scholar] [CrossRef]
- Wang, F.; Ma, X.; Wang, W.; Liu, J. Comparison of proximate composition, amino acid and fatty acid profiles in wild, pond- and cage-cultured longsnout catfish (Leiocassis longirostris). Int. J. Food Sci. Technol. 2012, 47, 1772–1776. [Google Scholar] [CrossRef]
- Mou, C.Y.; Li, Y.; Zhou, J.; Li, Q.; Zhou, B.; Wei, Z.; Luo, H.; Ke, H.Y.; Duan, Y.L.; Zhai, W.T. Genome-wide association study reveals growth-related markers and candidate genes for selection in Chinese longsnout catfish (Leiocassis longirostris). Aquaculture 2022, 560, 738513. [Google Scholar] [CrossRef]
- Cai, S.; Wu, Z.; Jian, J.; Lu, Y.; Tang, J. Characterization of pathogenic Aeromonas veronii bv. veronii associated with ulcerative syndrome from Chinese longsnout catfish (Leiocassis longirostris Günther). Braz. J. Microbiol. 2012, 1, 382–388. [Google Scholar]
- Xiao, Y.; Lei, Y.; Tang, S.L.; Zhang, H.J.; Wang, X.; Wang, X.P. Identification and antibiotic sensitivity of Edwardsiella ictaluri isolated from cultured Leiocassis longirostris. Chin. J. Fish. 2015, 28, 39–44. (In Chinese) [Google Scholar]
- Fonseca, E.L.; Ramos, N.d.V.; Andrade, B.G.N.; Morais, L.L.C.S.; Marin, M.F.A.; Vicente, A.C.P. A one-step multiplex PCR to identify Klebsiella pneumoniae, Klebsiella variicola, and Klebsiella quasipneumoniae in the clinical routine. Diagn. Microbiol. Infect. Dis. 2017, 4, 315–317. [Google Scholar] [CrossRef]
- Desai, S.; Sanghrajka, K.; Gajjar, D. High adhesion and increased cell death contribute to strong biofilm formation in Klebsiella pneumoniae. Pathogens 2019, 8, 277. [Google Scholar] [CrossRef]
- Laboratory Medicine Brach of Chinese Geriatrics Society; Shanghai Society of Laboratory Medicine; Clinical Microbiology Division of Shanghai Society of Microbiology. Expert consensus on laboratory testing for hypervirulent Klebsiella pneumoniae. Chin. J. Lab. Med. 2023, 46, 1164–1172. [Google Scholar]
- Zhang, T.; Yang, H.; Kang, L.; Gao, S.; Xin, W.; Yao, W.; Zhuang, X.; Ji, B.; Wang, J. Strong protection against ricin challenge induced by a novel modified ricin A-chain protein in mouse model. Hum. Vaccines Immunother. 2015, 11, 1779–1787. [Google Scholar] [CrossRef] [PubMed][Green Version]
- Clinical and Laboratory Standards Institute (CLSI). CLSI M100TM Performance Standards for Antimicrobial Susceptibility Testing, 34th ed.; Clinical and Laboratory Standards Institute: Malvern, PA, USA, 2024. [Google Scholar]
- Yoon, S.H.; Ha, S.M.; Lim, J.; Kwon, S.; Chun, J. A large-scale evaluation of algorithms to calculate average nucleotide identity. Antonie Leeuwenhoek 2017, 110, 1281–1286. [Google Scholar] [CrossRef] [PubMed]
- Meier-Kolthoff, J.P.; Carbasse, J.S.; Peinado-Olarte, R.L.; Göker, M. TYGS and LPSN: A database tandem for fast and reliable genome-based classification and nomenclature of prokaryotes. Nucleic Acids Res. 2021, 50, D801–D807. [Google Scholar] [CrossRef] [PubMed]
- Alikhan, N.F.; Petty, N.K.; Ben Zakour, N.L.; Beatson, S.A. BLAST Ring Image Generator (BRIG): Simple prokaryote genome comparisons. BMC Genom. 2011, 12, 402. [Google Scholar] [CrossRef] [PubMed]
- Lu, Y.; Feng, Y.; McNally, A.; Zong, Z. Occurrence of colistin-resistant hypervirulent Klebsiella variicola. J. Antimicrob. Chemother. 2018, 73, 3001–3004. [Google Scholar] [CrossRef]
- Yang, X.; Chan, E.W.-C.; Zhang, R.; Chen, S. A conjugative plasmid that augments virulence in Klebsiella pneumoniae. Nat. Microbiol. 2019, 4, 2039–2043. [Google Scholar] [CrossRef] [PubMed]
- Abbas, R.; Chakkour, M.; Zein, H.; Obaseki, E.F.; Obeid, S.T.; Jezzini, A.; Ghssein, G.; Ezzeddine, Z. General overview of Klebsiella pneumonia: Epidemiology and the role of siderophores in its pathogenicity. Biology 2024, 13, 78. [Google Scholar] [CrossRef] [PubMed]
- Guerra, M.E.S.; Destro, G.; Vieira, B.; Lima, A.S.; Ferraz, L.F.C.; Hakansson, A.P.; Darrieux, M.; Converso, T.R. Klebsiella pneumoniae biofilms and their role in disease pathogenesis. Front. Cell. Infect. Microbiol. 2022, 12, 877995. [Google Scholar] [CrossRef]
- Farzana, R.; Jones, L.S.; Rahman, A.; Andrey, D.O.; Sands, K.; Portal, E.; Watkins, W.J.; Pervin, M.; Banerjee, M.; Walsh, T.R. Outbreak of hypervirulent multidrug-resistant Klebsiella variicola causing high mortality in neonates in Bangladesh. Clin. Infect. Dis. 2019, 7, 1225–1227. [Google Scholar] [CrossRef]
- He, Z.E.; Cao, L.W.; Dai, Y.Y.; Lu, H.W.; Sun, B.L.; Li, Y.J. An abnormal multidrug-resistant and hypervirulent Klebsiella pneumoniae clinical isolate without rmpA or rmpA2. J. Univ. Sci. Technol. China 2023, 53, 54–59+70. (In Chinese) [Google Scholar] [CrossRef]
- Shen, L.F.; Hu, R.J.; Wan, L.; Huang, J. Whole-genome sequencing and virulence characteristics of Klebsiella variicola. Occup. Health 2024, 40, 732–738. (In Chinese) [Google Scholar]
- Crippa, C.; Pasquali, F.; Rodrigues, C.; De Cesare, A.; Lucchi, A.; Gambi, L.; Manfreda, G.; Brisse, S.; Palma, F. Genomic features of Klebsiella isolates from artisanal ready-to-eat food production facilities. Sci. Rep. 2023, 13, 10957. [Google Scholar] [CrossRef] [PubMed]
- Nikapitiya, C.; Chandrarathna, H.P.S.U.; Dias, M.K.H.M.; Lee, J.M.; Zoysa, D. Characterization and biocontrol efficacy of lytic phage (KPP-1) that infects multidrug resistant Klebsiella variicola. Braz. J. Microbiol. 2023, 54, 2509–2520. [Google Scholar] [CrossRef]
- Vieira, A.T.; Rocha, V.M.; Tavares, L.; Garcia, C.C.; Teixeira, M.M.; Oliveira, S.C.; Cassali, G.D.; Gamba, C.; Martins, F.S.; Nicoli, J.R. Control of Klebsiella pneumoniae pulmonary infection and immunomodulation by oral treatment with the commensal probiotic Bifidobacterium longum 51A. Microbes Infect. 2016, 18, 180–189. [Google Scholar] [CrossRef] [PubMed]
- Winnett, V.; Sirdaarta, J.; White, A.; Clarke, F.M.; Cock, I.E. Inhibition of Klebsiella pneumoniae growth by selected Australian plants: Natural approaches for the prevention and management of ankylosing spondylitis. Inflammopharmacology 2017, 25, 223–235. [Google Scholar] [CrossRef] [PubMed]
- Assoni, L.; Girardello, R.; Converso, T.R.; Darrieux, M. Current stage in the development of Klebsiella pneumoniae vaccines. Infect. Dis. Ther. 2021, 10, 2157–2175. [Google Scholar] [CrossRef]

| Gene | Primer | Sequence (5′-3′) | Length (bp) |
|---|---|---|---|
| rmpA | KvrmpA-F | AACTGGACTACCTCTGTTTC | 537 |
| KvrmpA-R | CTTGGCATGAGCCATCTTTCA | ||
| rmpA2 | rmpA2-F | CTTTATGTGCAATAAGGATGTT | 447 |
| rmpA2-R | CCTCCTGGAGAGTAAGCATT | ||
| magA | magA-F | TTAATGTCTTAGGGCCTTTGC | 720 |
| magA-R | ATTGACCATATTGCTCCGTTG | ||
| peg-344 | peg344-F | GCTCTTGAAACTATCCCTCCA | 388 |
| peg344-R | GGGCAATAACTCCCGTCCACT | ||
| iroB | iroB-F | CCCGATCTCATCATCTACCCTCC | 752 |
| iroB-R | GCCATTTCCGCCGCTACCTCT | ||
| iucB | iucB-F | ACTTTCAGCGGTGGTTCTCCC | 509 |
| iucB-R | GGTCAAAGGGTTGCCATGAATAG |
| Class | Antimicrobial Agents | Breakpoints (mm) * | Zone Diameter (mm) | Sensitivity | ||
|---|---|---|---|---|---|---|
| R | I | S | ||||
| Penicillins | Penicillin | ≤13 | 14~16 | ≥17 | 6.0 | R |
| Amoxicillin | ≤13 | 14~17 | ≥18 | 6.0 | R | |
| Cephalosporins | Cephalexin | ≤14 | 15~17 | ≥18 | 22.5 | S |
| Ceftriaxone | ≤19 | 20~22 | ≥23 | 35.5 | S | |
| Tetracyclines | Tetracycline | ≤11 | 12~14 | ≥15 | 17.5 | S |
| Doxycycline | ≤10 | 11~13 | ≥14 | 15.0 | S | |
| Amphenicols | Chloramphenicol | ≤12 | 13~17 | ≥18 | 6.0 | R |
| Florfenicol | ≤12 | 13~17 | ≥18 | 10.2 | R | |
| Quinolones | Enrofloxacin | ≤15 | 16~20 | ≥21 | 19.0 | I |
| Ofloxacin | ≤12 | 13~15 | ≥16 | 18.3 | S | |
| Norfloxacin | ≤12 | 13~16 | ≥17 | 15.6 | I | |
| Aminoglycosides | Gentamicin | ≤14 | 15~17 | ≥18 | 18.2 | S |
| Streptomycin | ≤11 | 12~14 | ≥15 | 15.3 | S | |
| Tobramycin | ≤12 | 13~14 | ≥15 | 19.1 | S | |
| Macrolides | Roxithromycin | ≤13 | 14~22 | ≥23 | 6.0 | R |
| Erythromycin | ≤13 | 14~22 | ≥23 | 6.0 | R | |
| Sulfonamides | Sulfamethoxazole/Trimethoprim | ≤10 | 11~15 | ≥16 | 23.3 | S |
| Sulfamethoxazole | ≤12 | 13~16 | ≥17 | 17.4 | S | |
| Lincosamides | Lincomycin | ≤9 | 10~15 | ≥16 | 6.0 | R |
| Glycopeptides | Vancomycin | ≤9 | 10~15 | ≥16 | 6.0 | R |
| Others | Fosfomycin | ≤12 | 13~15 | ≥16 | 19.7 | S |
| Klebsiella Strains | GenBank Accession No. | OrthoANIu Value (%) | dDDH (%) |
|---|---|---|---|
| K. variicola WCHKV030666 | CP027064 | 99.98 | 100 |
| K. variicola 15WZ-82 | CP032354 | 99.74 | 98.70 |
| K. variicola 13450 | CP030173 | 99.10 | 92.80 |
| K. pneumoniae str.Kp52.145 | FO834906 | 94.55 | 58.60 |
| K. pneumoniae BJCFK909 | CP034123 | 94.55 | 58.30 |
| K. quasipneumoniae A708 | CP026368 | 93.34 | 52.50 |
| Class | Virulence Factors | Genes |
|---|---|---|
| Adherence | Type III fimbriae | mrkA, mrkB, mrkC, mrkD, mrkF, mrkH, mrkI |
| Type I fimbriae | fimA, fimB, fimC, fimD, fimE, fimF, fimG, fimH, fimI, fimK | |
| Efflux pump | AcrAB | acrA, acrB |
| Iron uptake | Aerobactin | iutA |
| Ent siderophore | entA, entB, entC, entD, entE, entF, entS, fepA, fepB, fepC, fepD, fepG, fes | |
| Salmochelin | iroE, iroN | |
| Regulation | RcsAB | rcsA, rcsB |
| Secretion system | T6SS-I | clpV/tssH, dotU/tssL, hcp/tssD, icmF/tssM, impA/tssA, ompA, sciN/tssJ, tssF, tssG, vasE/tssK, vgrG/tssI, vipA/tssB, vipB/tssC |
| T6SS-II | clpV | |
| T6SS-III | impF | |
| Autotransporter | Contact-dependent inhibition CDI system | cdiA |
| Fimbrial adherence determinants | Stc | stcB, stcC |
| Sti | stiB | |
| Magnesium uptake | Mg2+ transport | mgtB |
| Resistance Mechanism | Antimicrobial Resistance Gene Family | Genes |
|---|---|---|
| Antibiotic efflux | MFS antibiotic efflux pump | kpnG, kpnH, emrR, H-NS, leuO |
| RND antibiotic efflux pump | CRP, rsmA, adeF, oqxA, baeR, marR, marA | |
| SMR antibiotic efflux pump | kpnE, kpnF, qacG | |
| ABC antibiotic efflux pump | lptD, msbA | |
| Antibiotic inactivation | Beta-lactamase | LEN-16 |
| Fosfomycin thiol transferase | fosA6 | |
| Antibiotic target alteration | phosphoethanolamine transferase | eptB, arnT |
| glycopeptide resistance gene | vanG | |
| Elfamycin-resistant | EF-Tu | |
| Fosfomycin-resistant | uhpT | |
| Penicillin-binding protein mutations | pbp3 | |
| Reduced permeability to antibiotic | Outer Membrane Porin | mdtQ |
| Reduced permeability to beta-lactams | ompK37 |
Disclaimer/Publisher’s Note: The statements, opinions and data contained in all publications are solely those of the individual author(s) and contributor(s) and not of MDPI and/or the editor(s). MDPI and/or the editor(s) disclaim responsibility for any injury to people or property resulting from any ideas, methods, instructions or products referred to in the content. |
© 2024 by the authors. Licensee MDPI, Basel, Switzerland. This article is an open access article distributed under the terms and conditions of the Creative Commons Attribution (CC BY) license (https://creativecommons.org/licenses/by/4.0/).
Share and Cite
Li, Q.; Yu, X.; Ye, L.; Hou, T.; Liu, Y.; Liu, G.; Wang, Q.; Zhang, D. Hypermucoviscous Multidrug-Resistant Klebsiella variicola Strain LL2208 Isolated from Chinese Longsnout Catfish (Leiocassis longirostris): Highly Similar to Human K. variicola Strains. Pathogens 2024, 13, 647. https://doi.org/10.3390/pathogens13080647
Li Q, Yu X, Ye L, Hou T, Liu Y, Liu G, Wang Q, Zhang D. Hypermucoviscous Multidrug-Resistant Klebsiella variicola Strain LL2208 Isolated from Chinese Longsnout Catfish (Leiocassis longirostris): Highly Similar to Human K. variicola Strains. Pathogens. 2024; 13(8):647. https://doi.org/10.3390/pathogens13080647
Chicago/Turabian StyleLi, Qingyong, Xin Yu, Lin Ye, Tongyu Hou, Yi Liu, Guiming Liu, Qing Wang, and Defeng Zhang. 2024. "Hypermucoviscous Multidrug-Resistant Klebsiella variicola Strain LL2208 Isolated from Chinese Longsnout Catfish (Leiocassis longirostris): Highly Similar to Human K. variicola Strains" Pathogens 13, no. 8: 647. https://doi.org/10.3390/pathogens13080647
APA StyleLi, Q., Yu, X., Ye, L., Hou, T., Liu, Y., Liu, G., Wang, Q., & Zhang, D. (2024). Hypermucoviscous Multidrug-Resistant Klebsiella variicola Strain LL2208 Isolated from Chinese Longsnout Catfish (Leiocassis longirostris): Highly Similar to Human K. variicola Strains. Pathogens, 13(8), 647. https://doi.org/10.3390/pathogens13080647

